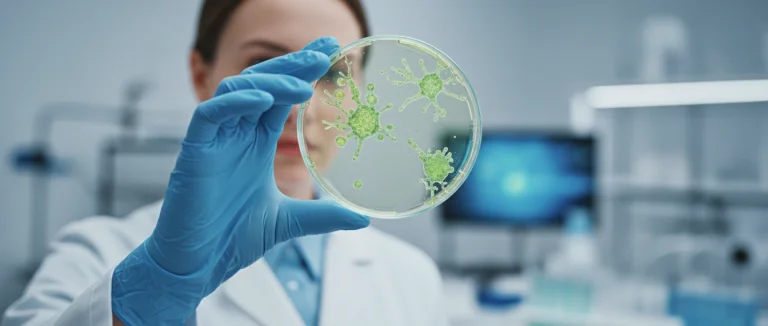
стем клетки в лабораторных условиях

Клеточная регенерация: современные подходы и возможности
-
Что такое клеточная регенерация и как она происходит
-
Стволовые клетки: ключ к регенеративной медицине
-
Клинические применения клеточной регенерации
-
Текущие исследования и будущее регенеративных технологий
-
Подготовка к лечению в Лив Хоспитал: что нужно знать
-
Почему выбирают Лив Хоспитал
Клеточная регенерация открывает новые горизонты в лечении хронических заболеваний и травм, позволяя восстанавливать повреждённые ткани без хирургического вмешательства. В последние годы научные исследования подтверждают эффективность этой технологии, особенно в сочетании со стволовыми клетками. Статья раскрывает механизмы процесса, клинические применения и перспективы развития, а также объясняет, как пациенты могут воспользоваться этими инновациями в Лив Хоспитал.
По данным международных исследований, более 70 % пациентов, прошедших курс регенеративной терапии, отмечают значительное улучшение качества жизни уже в первые три месяца. Это делает клеточную регенерацию одним из самых востребованных направлений современной медицины.
Мы рассмотрим, какие биологические процессы лежат в основе восстановления клеток, какие типы стволовых клеток применяются в клинической практике, а также какие заболевания уже успешно лечатся с помощью этих методов.
Что такое клеточная регенерация и как она происходит

Клеточная регенерация — это естественный процесс восстановления повреждённых или утраченных клеток организма за счёт активации внутренних биологических механизмов. Основные этапы включают детекцию повреждения, активацию сигнальных путей, пролиферацию и дифференциацию новых клеток, а затем их интеграцию в ткань.
Ключевыми факторами, запускающими регенерацию, являются ростовые факторы, такие как TGF‑β и FGF, а также микросреда, обеспечивающая необходимый уровень кислорода и питательных веществ. При нарушении любого из этих компонентов процесс может замедлиться или остановиться.
Основные биологические механизмы
- Сигнальный путь Wnt/β‑catenin, отвечающий за пролиферацию стволовых клеток.
- Механизм эпигенетической регуляции, влияющий на дифференциацию клеток.
- Активация иммунных клеток, поддерживающих восстановление тканей.
Эти механизмы взаимодействуют, обеспечивая быстрый и точный ответ организма на травму. Понимание их работы позволяет врачам разрабатывать целенаправленные терапии, усиливающие естественную регенерацию.
Стволовые клетки: ключ к регенеративной медицине
Стволовые клетки играют центральную роль в процессах восстановления, поскольку обладают способностью к самовоспроизводству и дифференциации в различные типы клеток. Существует несколько основных категорий, каждая из которых имеет свои преимущества в клинической практике.
Типы стволовых клеток
| Тип | Источник | Потенциал дифференциации | Ключевые применения |
|---|---|---|---|
| Эмбриональные (ESC) | Эмбрионы ранней стадии | Плюрипотентные | Исследования, редкие клинические протоколы |
| Плюрипотентные (iPSC) | Перепрограммированные взрослые клетки | Плюрипотентные | Персонализированная медицина |
| Мезенхимальные (MSC) | Костный мозг, жировая ткань | Мультипотентные | Ортопедия, кардиология, неврология |
| Гематопоэтические (HSC) | Костный мозг | Только кроветворные линии | Трансплантация крови, лечение лейкемий |
Для большинства клинических программ в Лив Хоспитал используют мезенхимальные стволовые клетки, поскольку они легко получают, обладают иммуносупрессивными свойствами и способны стимулировать регенерацию в различных тканях. Терапия стволовыми клетками (stem cell therapy) уже доказала эффективность при лечении артроза, ишемических инсультов и хронической сердечной недостаточности.
Клинические применения клеточной регенерации

В последние годы регенеративные подходы успешно внедрены в широкий спектр медицинских направлений. Ниже перечислены основные области применения, где клеточная регенерация уже демонстрирует ощутимые результаты.
- Ортопедия: инъекции MSC в суставы при остеоартрите снижают боль и восстанавливают хрящевую ткань.
- Неврология: трансплантация стволовых клеток в поражённые участки мозга способствует нейрогенезу после инсульта.
- Кардиология: введение стволовых клеток в инфарктную зону улучшает контрактильность миокарда.
- Эндокринология: регенерация поджелудочной железы открывает перспективы лечения диабета 2 типа.
- Дерматология: использование стволовых клеток в лечении ожогов ускоряет заживление и уменьшает рубцевание.
Каждое направление требует индивидуального протокола, включающего оценку состояния пациента, подбор типа стволовых клеток и план последующего наблюдения. В Лив Хоспитал такие программы разрабатываются мультидисциплинарными командами, обеспечивая высокий уровень безопасности и эффективности.
Текущие исследования и будущее регенеративных технологий
Научные группы по всему миру активно исследуют новые способы ускорения клеточной регенерации. Ключевые направления включают генетическое редактирование, биопринтинг тканей и применение наноматериалов.
Генетическое редактирование
Технологии CRISPR/Cas9 позволяют вносить точные изменения в ДНК стволовых клеток, повышая их способность к дифференциации и выживанию после трансплантации. Первичные клинические испытания уже показывают улучшенные результаты при лечении генетических заболеваний.
Биоинженерия и 3D‑печать
Создание трёхмерных биосканов с использованием живых клеток открывает возможность восстановления сложных органов, таких как печень или сердце. Такие прототипы тестируются в лабораториях и могут стать основой для будущих трансплантатов.
В ближайшие годы ожидается рост количества одобренных регенеративных процедур, а также расширение доступа к этим методам для международных пациентов, ищущих передовые решения в Лив Хоспитал.
Подготовка к лечению в Лив Хоспитал: что нужно знать
Для иностранных пациентов процесс подготовки к терапии стволовыми клетками в Лив Хоспитал максимально упрощён. Ниже перечислены основные шаги, которые помогут пройти лечение без лишних задержек.
- Онлайн‑консультация с врачом‑специалистом для оценки показаний.
- Сбор медицинской документации (результаты анализов, истории болезней) и её перевод.
- Подбор оптимального протокола лечения и согласование стоимости.
- Организация трансфера из аэропорта и помощь с проживанием.
- Подготовка к процедуре: диета, приём предоперационных препаратов.
- Постлечебный мониторинг и поддержка после выписки.
Команда Лив Хоспитал обеспечивает сопровождение на каждом этапе, включая услуги переводчика и помощь в оформлении визы, что делает процесс комфортным даже для пациентов, приезжающих издалёк.
Почему выбирают Лив Хоспитал
Лив Хоспитал — это аккредитованная JCI группа частных больниц в Стамбуле, специализирующаяся на регенеративной медицине и терапии стволовыми клетками. Мы предлагаем комплексный подход: от первичной диагностики до полного постлечебного наблюдения, гарантируя высокий уровень безопасности и персонализированное лечение для международных пациентов.
Готовы открыть новые возможности восстановления своего организма? Свяжитесь с нашими специалистами уже сегодня, чтобы получить персональную программу клеточной регенерации в Лив Хоспитал.
Часто задаваемые вопросы
Клеточная регенерация представляет собой совокупность процессов, включающих детекцию повреждения, активацию сигнальных путей (например, Wnt/β‑catenin), пролиферацию и дифференциацию новых клеток, а также их интеграцию в ткань. Ключевыми факторами являются ростовые факторы TGF‑β, FGF и оптимальная микросреда с достаточным кислородом и питательными веществами. При нарушении любого из этих компонентов процесс может замедлиться, поэтому в клинической практике используют препараты и стволовые клетки, усиливающие естественную регенерацию.
Эмбриональные (ESC) обладают плюрипотентностью, но их использование ограничено. Индуцированные плюрипотентные (iPSC) получаются из перепрограммированных взрослых клеток и позволяют персонализировать лечение. Мезенхимальные стволовые клетки (MSC) из костного мозга или жировой ткани легко получают и они обладают иммуносупрессивными свойствами, что делает их предпочтительными в клиниках, включая Лив Хоспитал. Гематопоэтические (HSC) применяются в трансплантации крови и лечении лейкемий.
Клинические программы включают инъекции MSC в суставы при остеоартрите, трансплантацию стволовых клеток в мозг для восстановления после инсульта, введение клеток в инфарктную зону сердца для улучшения функции миокарда, регенерацию поджелудочной железы при диабете 2 типа и применение стволовых клеток в дерматологии для ускорения заживления ожогов. Каждый протокол адаптируется под конкретного пациента, учитывая тип клетки, дозировку и схему наблюдения.
Иностранный пациент сначала проходит онлайн‑консультацию с врачом‑специалистом, после чего собирает результаты анализов и историю болезни, которые переводятся на английский/турецкий язык. Затем команда подбирает оптимальный протокол лечения, согласовывает стоимость и организует трансфер из аэропорта, а также помогает с проживанием и визой. Перед процедурой пациент готовится к диете и приёму предоперационных препаратов, а после выписки получает постлечебный мониторинг и поддержку переводчика.
Технология CRISPR/Cas9 позволяет вносить точные изменения в ДНК стволовых клеток, повышая их выживаемость и дифференцирующий потенциал. Биоинженерия и 3D‑печать используют живые клетки для создания тканевых конструкций, потенциально заменяющих органы, такие как печень или сердце. Наноматериалы, включая биосовместимые гидрогели, служат каркасом для клеток, улучшая их прикрепление и рост. Все эти направления находятся в активных клинических испытаниях и обещают расширить спектр доступных регенеративных процедур.
Лив Хоспитал обладает международной аккредитацией JCI, что гарантирует высокий уровень качества и безопасности. Клиника специализируется на регенеративной медицине, предлагая персонализированные программы от диагностики до постлечебного наблюдения. Врачи используют проверенные протоколы с мезенхимальными стволовыми клетками, а также новейшие технологии, такие как CRISPR и 3D‑печать. Для международных пациентов предоставляются услуги переводчика, помощь с визой и трансфером, что делает процесс лечения комфортным и доступным.
* Содержимое нашего сайта предназначено только для информационных целей. Обязательно обратитесь к врачу для диагностики и лечения. В содержание страницы не включены элементы, содержащие информацию о терапевтических медицинских услугах в Лив Госпитале.













